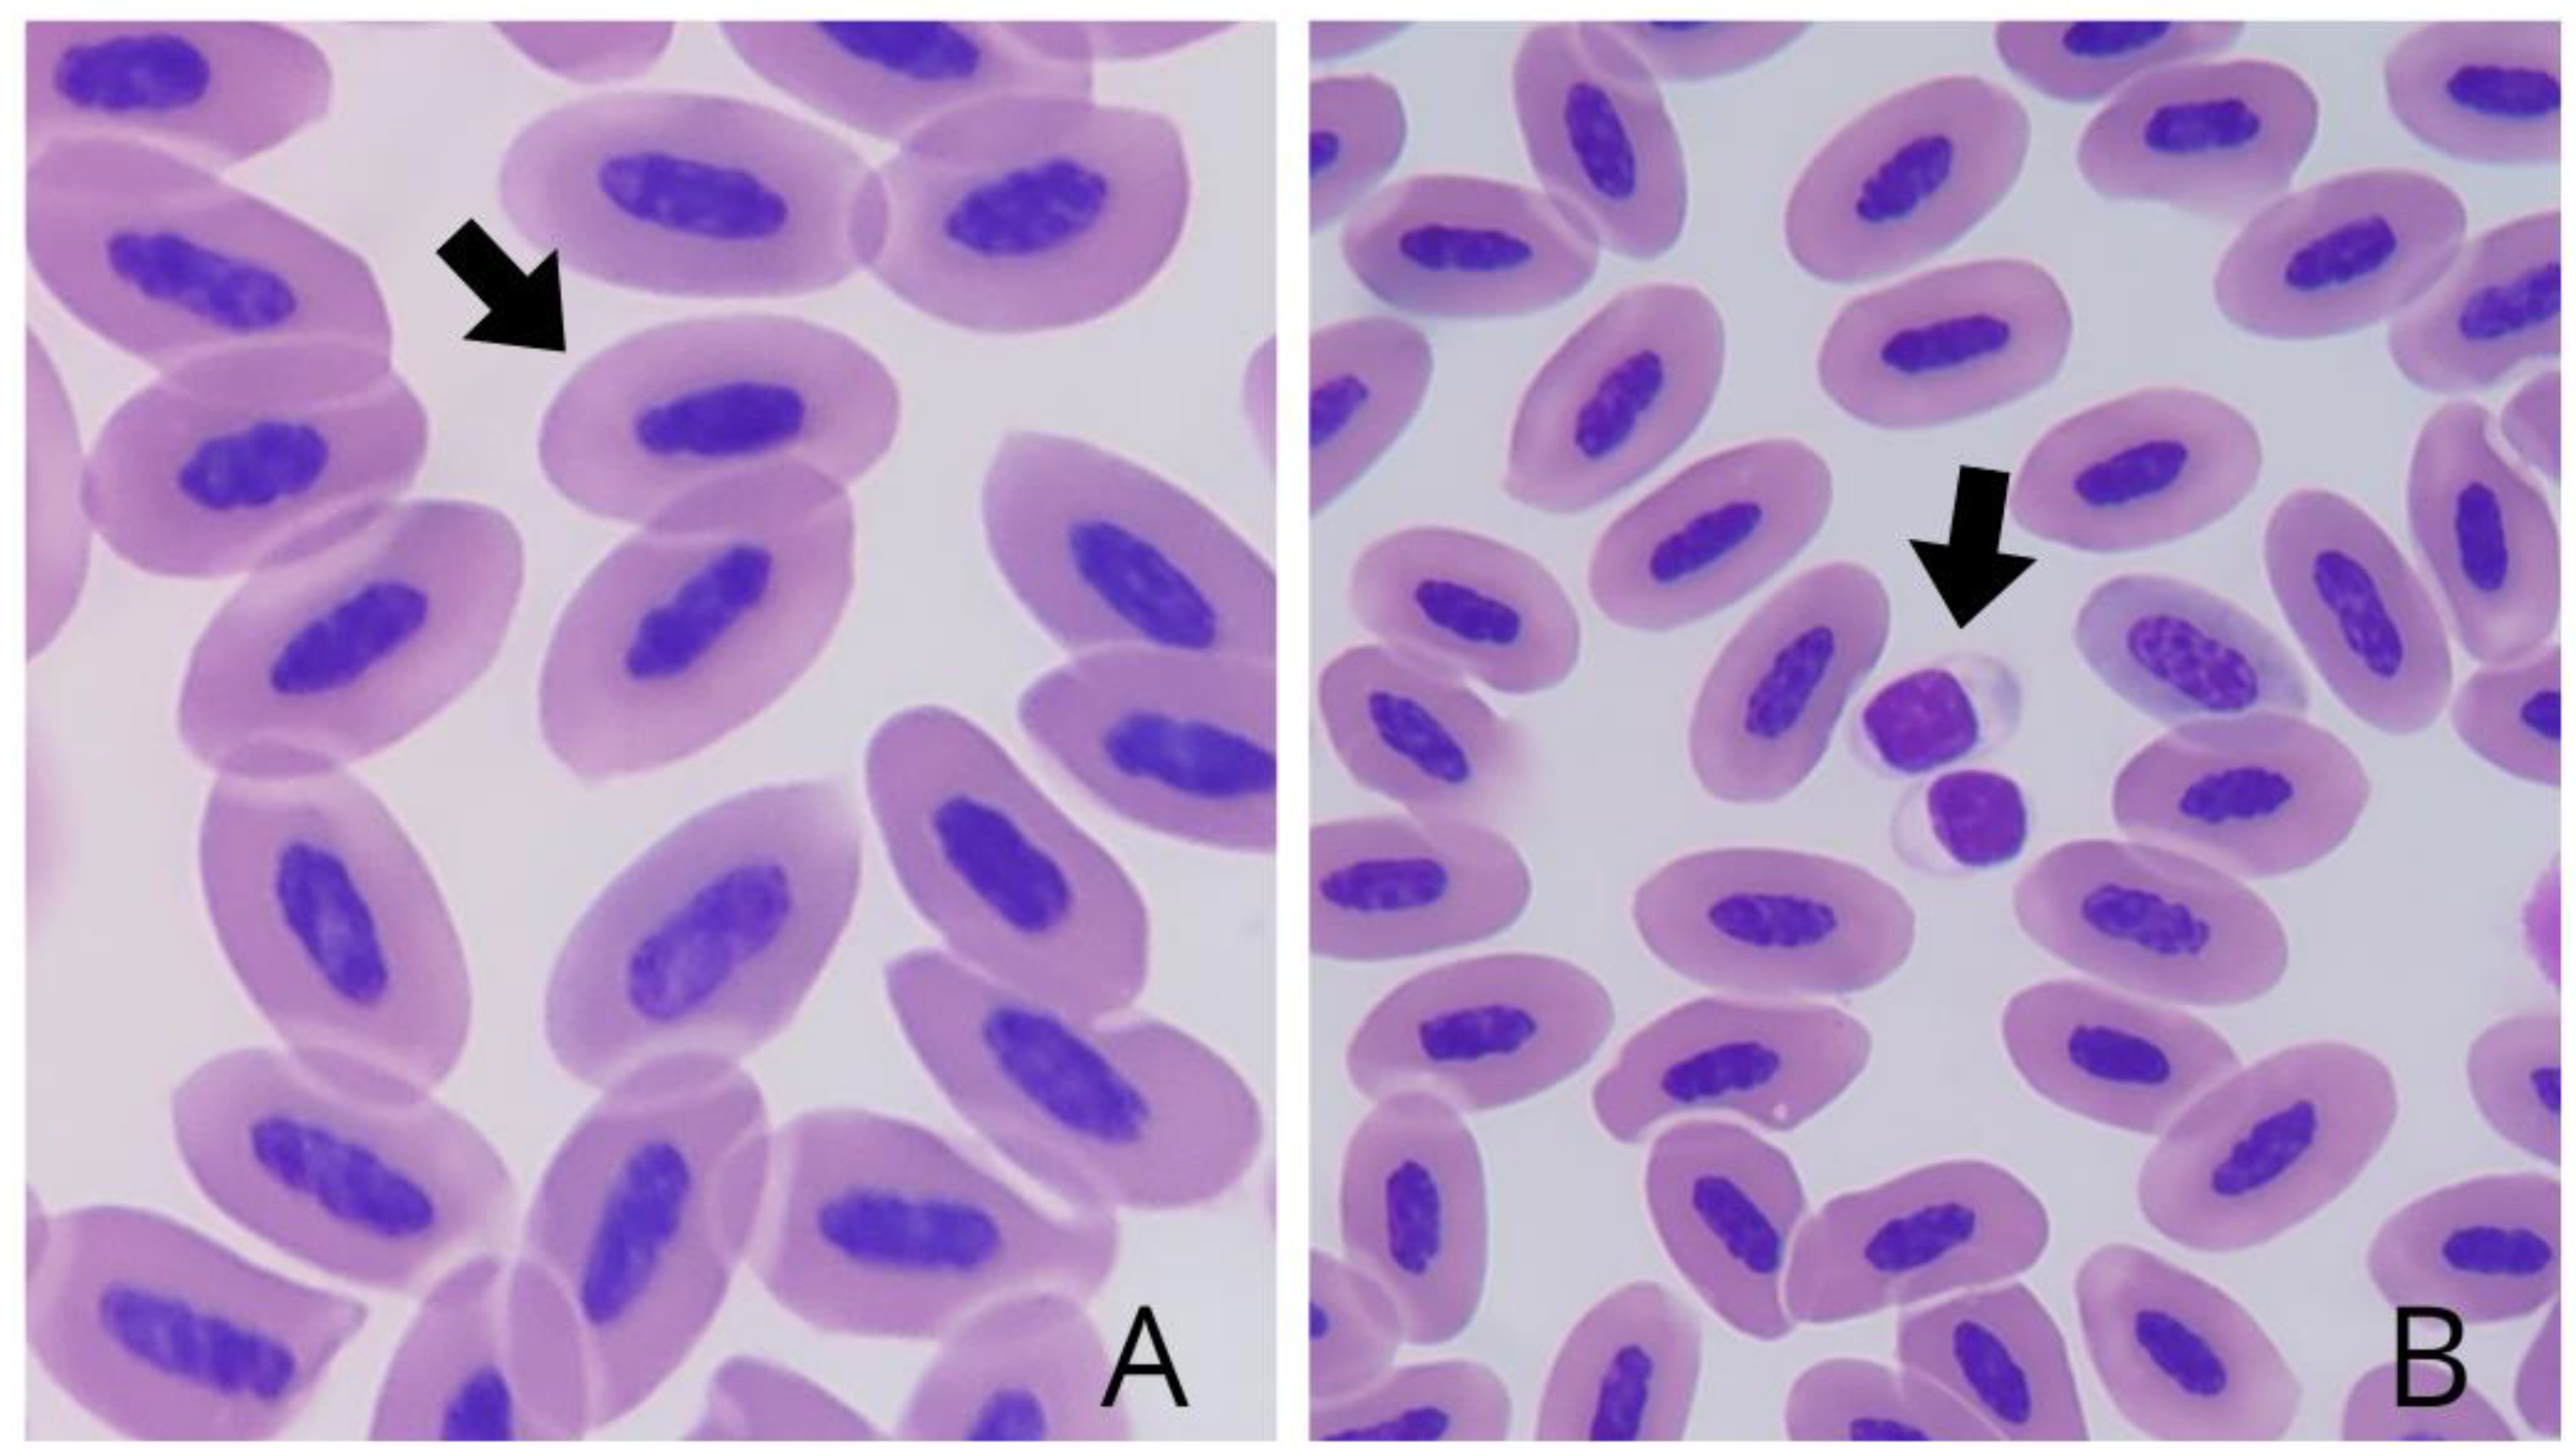
Preprints 118827 g001
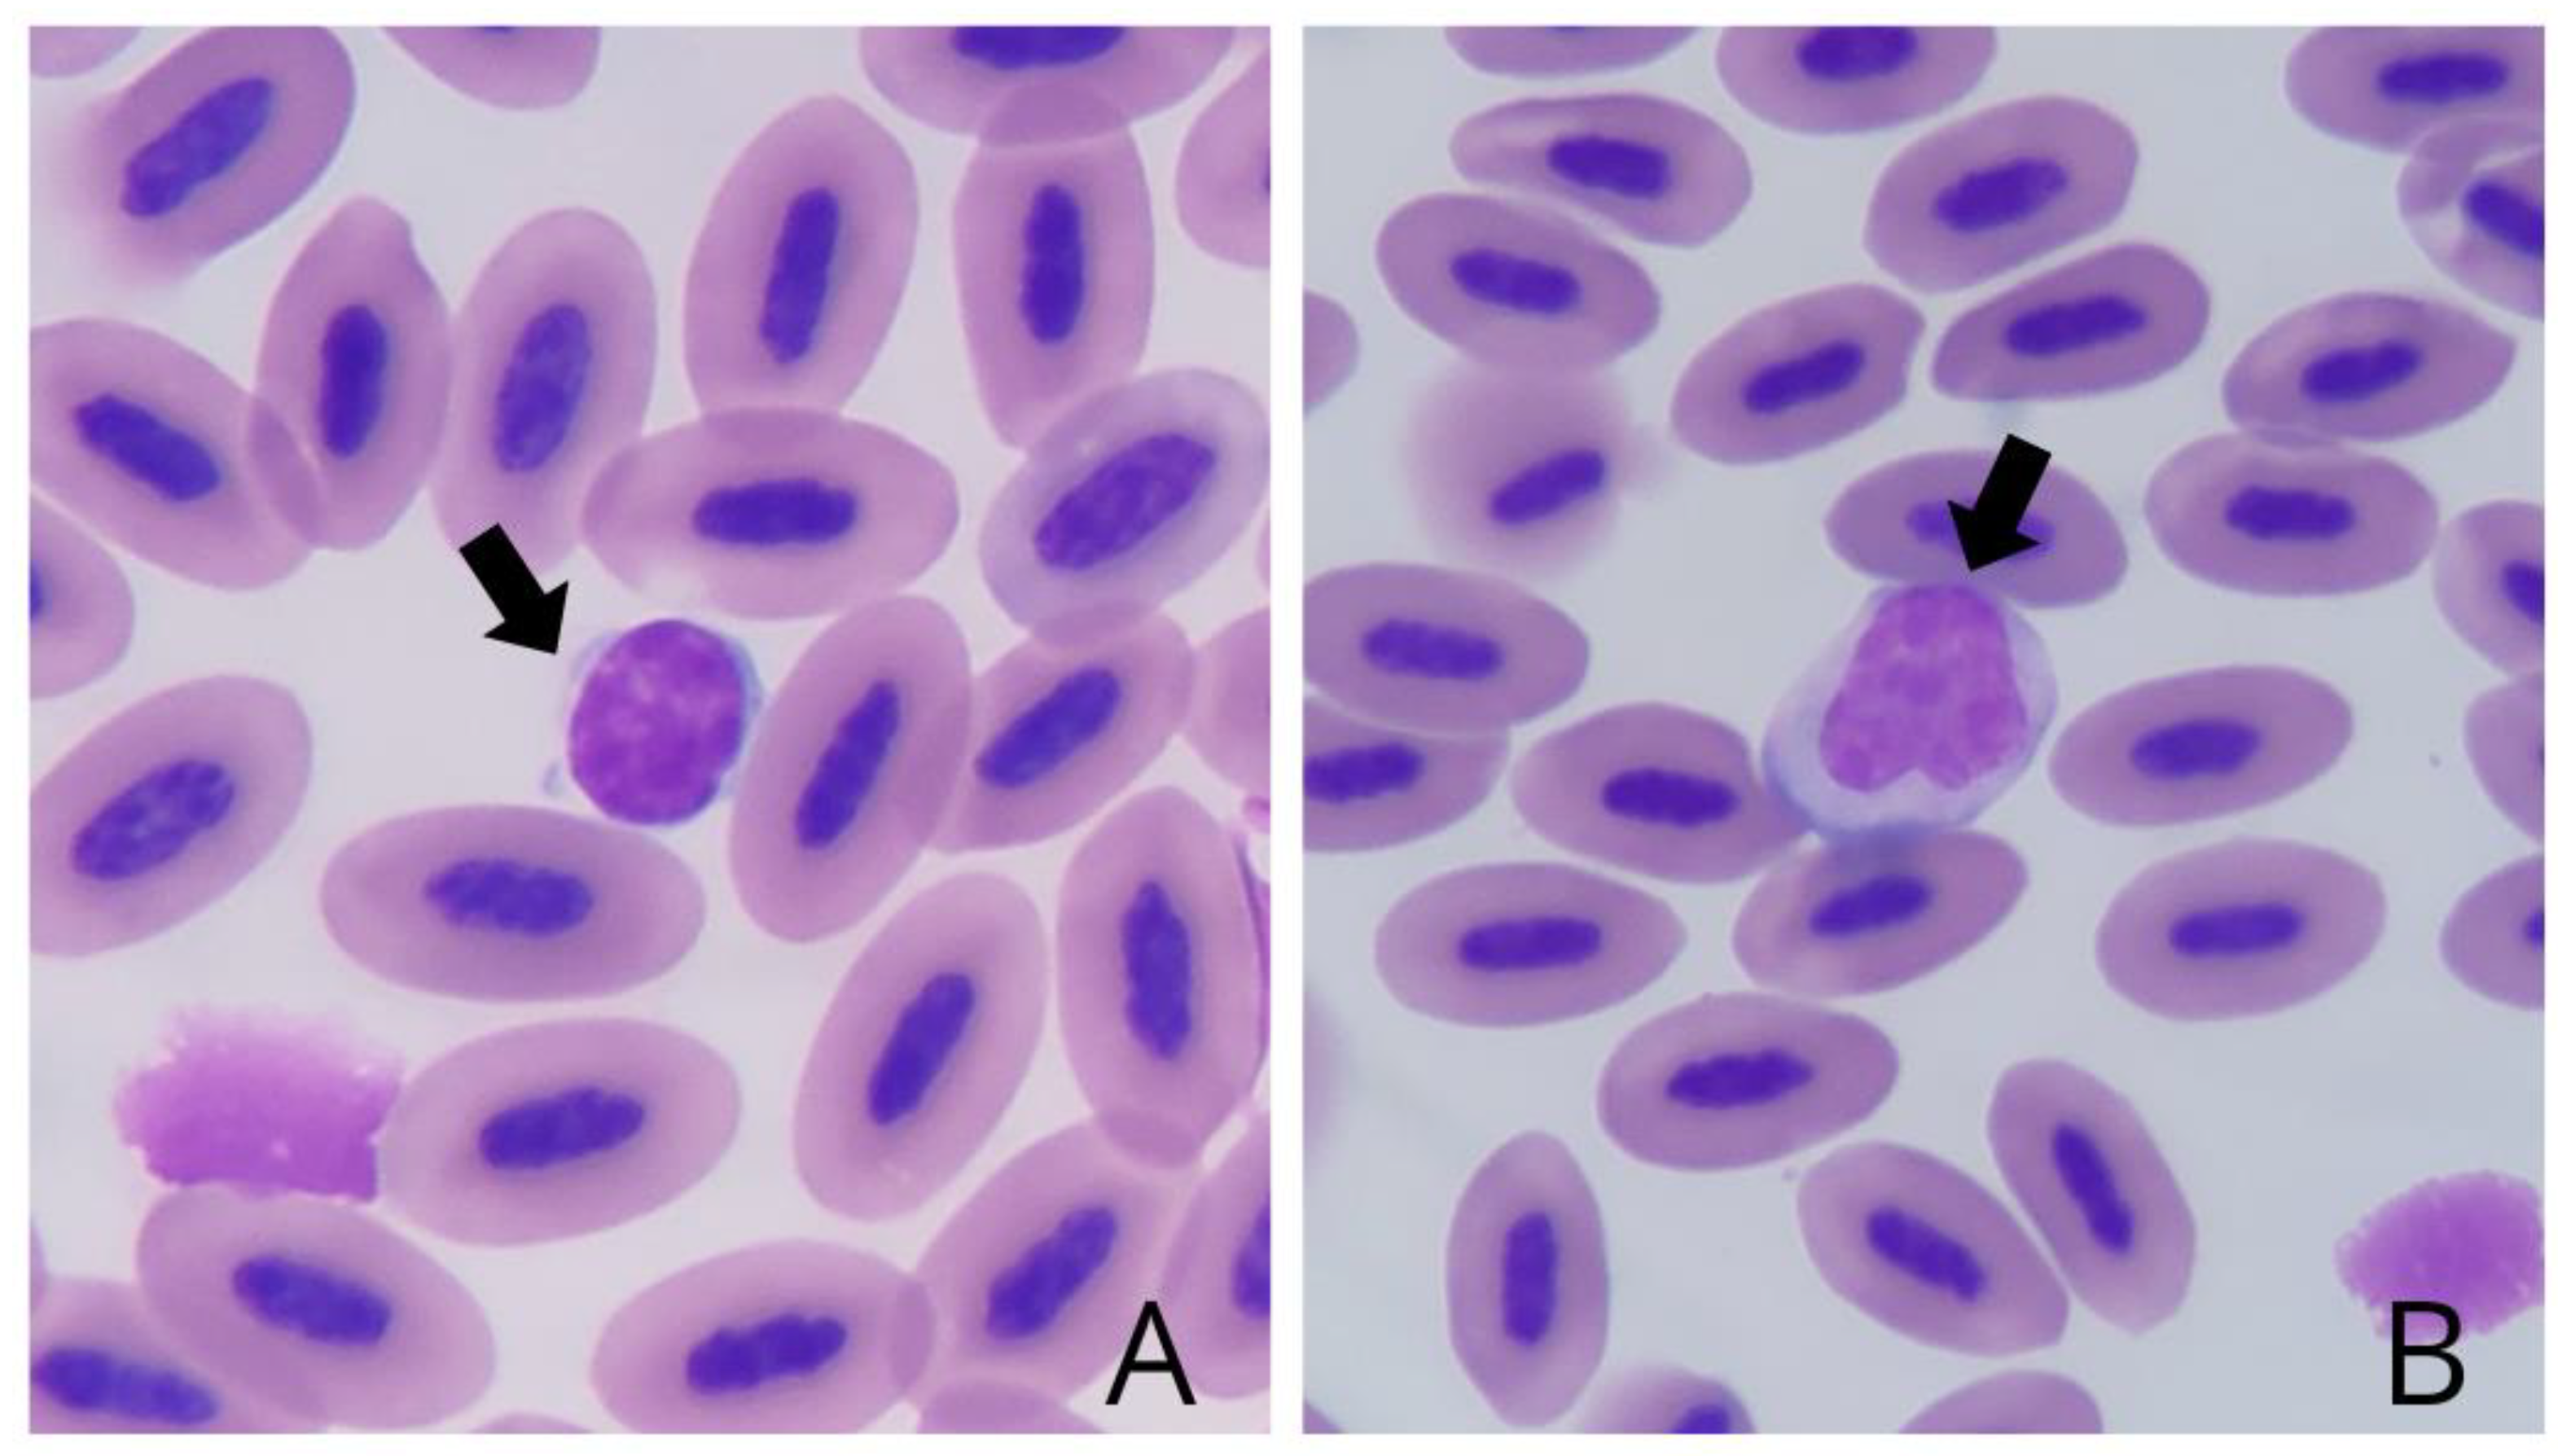
Preprints 118827 g003

1. Introduction
In Brazil, the avian fauna is represented by 102 families and 1.971 recognized species [
1]. Birds from the Psittacidae family are routinely raised as pets due to their highly developed cognition and sociability [
2]. Among them, the gender Amazona has the largest number of species in the family, 12 of which are found in Brazilian territory [
1], including Amazona amazonica [
3], popularly known as the mangrove parrot.
The specific epithet of the name “amazonica” is related to the Amazon River [
4] due to its geographic distribution throughout the Amazon rainforest [
5]. The populations of these birds have been victims of habitat destruction and illegal capture [
7] and, thus, occupy the fourth place in the ranking of parrot species most seized by the Brazilian Institute for the Environment and Renewable Natural Resources (IBAMA) [
8].
When treated in veterinary establishments, monitoring the health of these birds or any other birds coming from conservation, commercial, or scientific breeders [
9], an early diagnosis of health status only through physical examination becomes challenging, since it is common for birds to hide clinical signs as a protective mechanism. In this context, laboratory tests can contribute to determining the diagnosis, prognosis, and appropriate treatment [
2].
However, the lack of publication of reference values in several avian species, whether sick or healthy, is a limiting factor in the laboratory evaluation of these animals [
10]. Furthermore, possible variations in values due to genetic factors, sex, age, physiological state, territory, habitat, and others must be considered [
11]. In this context, the use of hematological values from individuals from different geographic regions than the specimens under evaluation, even if they are from the same reference species, is not recommended by some authors [
12].
Regarding studies on the hematology of A. amazonica kept under human care, only a few have been published on gender. However, in other regions of the country [
14] or even the world [
15,
16], there are no records relating to specimens from the Amazon biome. Thus, intending to compile a list of laboratory data for the species living in the Amazon biome, this research presents hematological reference intervals for mangrove parrots (Amazona amazonica) from a holding facility located in northern Brazil, state of Pará.
2. Materials and Methods
The research followed international animal welfare standards and was approved by the Animal Use Ethics Committee of the Federal University of Pará (UFPA) (protocol 4500260123). The SISBIO license was issued following Ordinance No. 748 of the Chico Mendes Institute for Biodiversity Conservation (ICMBio) of September 19, 2022, for the collection of ex-situ biological material
- b.
Sample collection
Thirty-two adult specimens of Amazona amazonica with good nutritional conditions considered clinically healthy by history and clinical examination were used. The physical aspects evaluated and recorded during the clinical examination were abnormal skin turgor, areas of abnormal apteria, presence of ectoparasites, inadequate body score, and dyspnea, in addition to behavior during blood collection. Animals that presented such alterations were excluded from the study. The birds were kept in collectively screened enclosures in wooded areas that mimic their natural habitat with exposure to the sun at certain times of the day, with an average capacity of two animals per enclosure, and are under the responsibility of a wildlife care facility located in Terra Alta, Pará, Amazon, Brazil.
The diet consisted of fruits such as orange, açaí, papaya, guava, and banana, previously selected and sanitized. Sex was not determined due to limitations in recording or sample volume, and the animals were fasting during collection.
Blood collection was performed during the period of the highest rainfall in the region, equivalent to an average of 56 mm³ per day [
17], and was concentrated in the morning. The birds were physically restrained, and blood was collected after antisepsis of the skin covering the right or left jugular vein with 70% alcohol. A total of 0.4 ml of whole blood was collected from each bird using a 3 mL syringe and a 24G needle (0.55X20mm) and immediately stored in a tube with ethylenediaminetetraacetic acid (EDTA), being refrigerated for a maximum of 4 hours until further analysis at the Veterinary Clinical Pathology Laboratory of the Federal University of Pará. Two blood smears were prepared from each sample immediately after collection, with blood without anticoagulant to avoid possible morphological and staining alterations. The smears were dried at room temperature.
- c.
Sample processing
The total erythrocyte, leukocyte, and thrombocyte count was performed manually [
18], using Natt-Herrick diluent dye (Êxodo Científica®) and a hemocytometer. Hemoglobin was measured spectrophotometrically using a HemoCue® Hb 201+ portable analyzer [
19]. The hematimetric indices Mean Corpuscular Volume (MCV), Mean Corpuscular Hemoglobin Concentration (MCHC), and Mean Corpuscular Hemoglobin (MCH) were calculated according to the recommendations in the literature [
18].
Hematocrit was determined by centrifuging whole blood in glass microhematocrit tubes for 5 minutes at 11,680g (Benfer® Microhematocrit Centrifuge) and the concentration of total plasma proteins (TPP) was measured using the refractometry method [
18].
Blood smears were stained with MAY GRUNWALD - GIEMSA dye (Bioclin®) and analyzed under an optical microscope for cell morphology, differential leukocyte count, and search for hemoparasites under an optical microscope at 1000x magnification.
- d.
Statistical Analysis
All analyses were performed using Microsoft® Excel with the Reference Value Advisor add-in (version 2.1), which follows the guidelines of the Clinical & Laboratory Standards Institute (CLSI) and the American Society for Veterinary Clinical Pathology (ASCVP).
The data obtained were subjected to descriptive statistics, determining the mean, median, standard deviation and minimum and maximum values. The assessment of data normality was performed using the Anderson-Darling method, with the production of frequency histograms and Q-Q plots for internal data analysis.
The upper and lower reference limits (RL) were calculated using the robust and standard methods after Box-Cox transformation, as suggested by the program, based on a 90% confidence interval. Outliers were removed, when necessary, using the Dixon-Reed and Tukey tests.
3. Results
The data on total counts, mean, median, standard deviation, minimum and maximum values, and the upper and lower reference limits of each variable analyzed are shown in
Table 1.
Morphological analysis revealed erythrocytes (
Figure 1A) with elliptical morphology, light pink cytoplasm, and elliptical nucleus with intense basophilic staining in the center of the cell. Thrombocytes (
Figure 1B) were identified both isolated and in groups, consisting of small cells with cytoplasm that were difficult to visualize due to their lighter color and a high nucleus:cytoplasm ratio, in addition to a rounded nucleus characterized by densely aggregated chromatin and evident basophilic staining.
The leukocytes observed were heterophilic granulocytes, eosinophils and basophils, and mononuclear lymphocytes and monocytes. The heterophils (
Figure 2A) of A. amazonica were morphologically round, with a non-staining cytoplasm and dispersed cytoplasmic granules in the shape of fusiform rods. The heterophils had a lilac-colored bilobed nucleus.
The eosinophils (
Figure 2B) had a size and morphology compatible with heterophils, with a rounded configuration. They had more grouped and rounded cytoplasmic granules, with a bilobed nucleus with markedly eosinophilic staining..
The basophils (
Figure 2C) exhibited a rounded morphology. Scattered cytoplasmic granules were observed throughout the cytoplasm, which were distributed evenly, overlapping the nuclear region of the cell. The basophil nuclei were non-lobulated and characterized by an intense basophilic staining.
The lymphocytes (
Figure 3A) also presented a predominantly rounded morphology, light blue cytoplasm, and a basophilic and non-lobed central nucleus. The monocytes (
Figure 3B) were large cells with an irregular shape, with cytoplasmic vacuoles in some specimens and an asymmetrical nucleus of lilac hue.
The samples were all negative for hemiparasites on smear slides.
4. Discussion
To the author's knowledge, this is the first study that addresses the hematological intervals of mangrove parrots (Amazona amazonica) from wildlife management establishments in the Amazon Biome.
The erythrogram results demonstrated that the mean, minimum, and maximum values of erythrocytes and hematocrit of A. amazonica kept in captivity in the Amazon biome were lower when compared to data from the same species raised in Florida, United States [
16]. Furthermore, the lower and upper reference values limits for erythrocytes were also lower, while the hematocrit values remained similar. Given these results, it is imperative to consider the bioclimatic diversities between the biomes in which the animals in the studies are inserted, along with disparities in the adopted diet. In one study conducted in the United States [
11], the animals were fed fruits, vegetables, and commercial feed, in contrast to the dietary conditions of the birds in the present study, which were fed only fruits. Such differences, therefore, may contribute to the variations observed in hematological variables between the two studies.
Regarding hemoglobin concentration, the values of the present study compared with those reported for mangrove parrots from the Colombian Andean-Amazonian transition area, presented higher mean, minimum, and maximum values, as well as hematocrit values, while the mean erythrocyte values observed were lower [
15]. Such discrepancies in data can be attributed to the distinct geographic location of these animals since hematological variables are susceptible to the influence of territorial characteristics, as well as sex, age, and physiological state [
11].
Relative to the hematometric indices MCV, MCHC, and MCH, it was observed a tendency for these values to vary in different species of psittacines [
18]. The MCV and MCHC values found in A. amazonica in this study revealed disparities in relation to the values previously described [
20] for individuals of the same species kept in captivity at the Barcelona Zoo.
Furthermore, it was found that these values were different from those recorded for A. rhodocorytha [
21] and A. vinacea [
22]. Thus, there is a clear variation between individuals of the same species and gender. These differences are due to the fact that such indices result from mathematical calculations based on erythrocyte, hemoglobin, and hematocrit values [
10], which in turn may change due to factors intrinsic and extrinsic to the individuals. These fluctuations can also be attributed to differences between species [
11], corroborating the results obtained in the present study.
In the leukogram, a difference was observed in the mean, minimum, and maximum values and lower and upper reference limits in the global leukocyte count when contrasted with studies conducted on individuals of the same species [
15,
16]. These results confirm that there are differences in hematological values of specimens that, although from the same species and considered healthy during the studies, are kept or live in different environments such as the Colombian Amazonian Andean transition area [
15], the United States [
16], or the Brazilian Amazon.
As demonstrated in previous studies, most psittacines exhibit heterophils as predominant leukocyte cells, as observed in Psittacula krameri [
23] and Psittacus erithacus [
24]. However, in birds of the Amazona gender, a smaller proportion of heterophils is notable, which does not characterize neutropenia under healthy conditions since these birds present lymphocytes as predominant leukocytes [
25]. This particularity was observed in the present study, in which a predominance of lymphocytes about other leukocyte cells, a finding already described in the species Amazona amazonica [
16].
The occurrence of changes in the proportion of heterophils and lymphocytes is commonly observed in animals affected by diseases associated with antigenic stimulation [
26] or stress situations [
18], manifesting through conditions such as neutropenia, heterophilia, lymphopenia, and lymphocytosis. These variations, as well as those evidenced in the present and other studies already documented in the literature [
15,
16], can also be observed between different species in healthy individuals. For example, a condition considered lymphocytosis in an individual of the species P. krameri [
23] can be regarded as regular in A. amazonica, as observed in the present study. Therefore, when using hematological reference values to evaluate a given species, it is essential to understand what is considered normal within that species under specific conditions.
Heterophils were the second most frequent leukocytes, followed by monocytes, which is in agreement with records in the literature [
16] and in both studies, the animals included were considered healthy. Subsequently, basophils and, lastly, eosinophils were observed, the latter being considered scarce in blood smears of birds [
27], with generally reduced concentrations [
23], which justifies their low count in the study in question. Notably, the absence of band neutrophils is justified by the healthy physiological state of the animals at the time of sample collection, which was evidenced by the history, physical examination, and absence of hemiparasites in the blood smear, since the presence of these cells is associated with pathological conditions [
18].
Regarding the types and morphological characteristics of blood cells present in individuals of the Amazona amazonica species, the present study found agreement with the cellular characteristics previously described in birds from other species and gender [
18]. The identified cellular components resemble the typologies and morphological characteristics observed in other psittacines, as previously demonstrated [
23] in P. krameri and M. undulatus.
Thrombocyte count is rarely used in avian medicine and, thus, is poorly documented in hematological studies. This limitation can be attributed to the intrinsic capacity of these cells to agglutinate, which does not allow obtaining truly representative values [
18]. However, these results are important to provide an idea of the condition of the animals being evaluated, with the presence of thrombocytes in the analysis being classified as decreased, adequate, or increased [
10].
Significant variations in the total avian thrombocyte count have already been documented, such as in the species Amazona vinacea, which exhibited variations between 17,000 and 116,000/µL [
22]. The present study also found significant differences between the lower and upper reference limits, ranging from 11,119.1 to 51,139.6/µL, respectively, although aggregated thrombocytes were observed on the smear slide.
Regarding the analysis of total plasma protein concentrations, significant variability was observed in the values compared with those measured in other psittacines. The values identified in the species A. amazonica in the present study presented discrepancies about other birds belonging to the same genus, such as A. vinacea and A. rhodocorytha [
21,
22]. The oscillations in the concentrations of these proteins in clinically healthy birds may be influenced by physiological factors, such as the reproductive period, which, however, did not apply to the animals in the study, and age, which was standardized as an adult according to the time the animals remained in the aviary. In addition, these concentrations may undergo changes associated with pathological conditions, but no pathological state was found in the physical evaluation and medical history of the animals included in the study, which appeared clinically healthy in the blood collection. Therefore, this scenario highlights that variations for this analyte may occur even about the same animal species [
18].
A limitation of the present study was the reduced number of animals available under identical handling conditions for conducting the research. Despite this limitation, it was possible to perform the analyses on 32 specimens of A. amazonica that were subjected to the same climatic conditions, with standardized feeding and considered adults due to the time spent in the breeding facility; however, it was not possible to perform the analysis to determine the sex of the animals.
No blood parasites were found in blood smears, and this assessment contributed to the animals' good health status.
Author Contributions
- Conceptualization, Project administration, Writing - review & editing, Investigation, Methodology: Natália da Silva e Silva Silveira¹ - Conceptualization, Writing - review & editing: Cinthia Távora de Albuquerque Lopes. - Investigation, Methodology, Writing - original draft: Dallyth Maia da Costa Santos¹*, Francisco Wanderson Bizerra Lima², Nailson de Andrade Neri Júnior¹, - Investigation, Methodology, Writing - original draft: Milena Barbosa Casari², Analiel Serruya¹, Thyele Chaves da Silva¹, Leonardo Carvalho Costa¹, Anna Klara de Matos Guerreiro¹, Luis Edson Silva Moura¹, Mayra Coelho¹, Mário José Costa Carneiro¹, Cintya Renata Santana de Barros², - Formal analysis, Methodology, Writing - review & editing: Paulo Cesar Magalhães-Matos³ and Roberto Thiesen². All authors read and agreed with the published version of the manuscript.